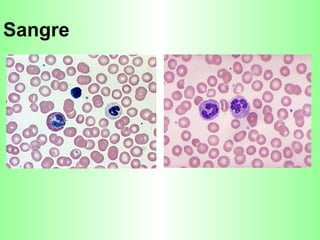
Sangre

El documento describe los cuatro tejidos básicos del cuerpo humano: epitelial, conectivo, muscular y nervioso. Explica que los tejidos son conjuntos organizados de células que funcionan de forma colectiva para realizar una tarea específica, y que varios tejidos trabajan juntos para formar órganos y sistemas de órganos. Luego procede a describir los diferentes tipos de tejidos epiteliales, conectivos, musculares y nerviosos.